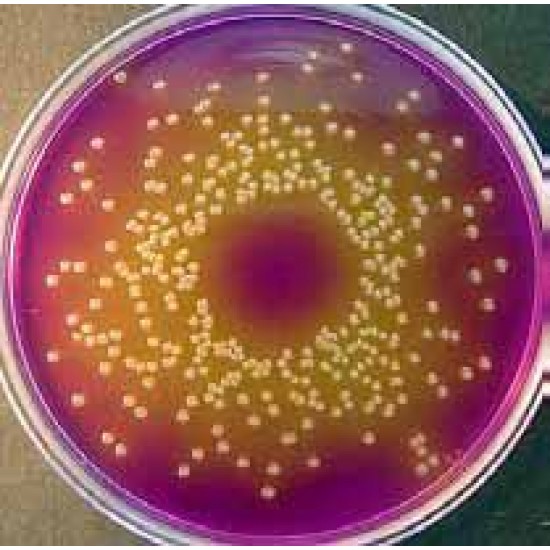
Dextrose Bromocresol Purple 500Gm

Dextrose Bromocresol Purple 500Gm
Dear Customer: The items available in our warehouses are supplied immediately, and the unavailable are provided and imported from the manufacturer, and you will be contacted via e-mail to determine the date of delivery
810.29 SAR
Ex Tax: 704.60 SAR
- Stock: Pre Order
- Model: Techno
- SKU: Dextrose Bromocresol Purple 500Gm